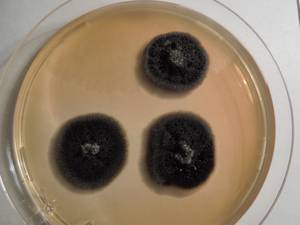
MSU_FS-01549 01, Район Тан Фу (Tân Phú districts), Đồng Nai province (Vietnam)
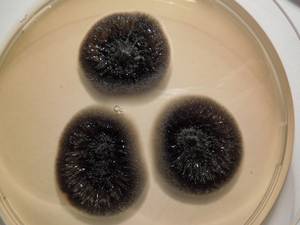
MSU_FS-01491 01, Район Тан Фу (Tân Phú districts), Đồng Nai province (Vietnam)

Total items: 4
Total pages: 1
Organisms

- Specimen ID
- 0000000905696
- Species
- Coniothyrium sp.
- Strain
- MSU_FS-02620
- Place of isolation
- Район Кон Плонг (Kon Plông district), Kon Tum province (Vietnam)
- Placename
- Манг Кань (Măng Cành commune)

- Specimen ID
- 0000000904642
- Species
- Coniothyrium sp.
- Strain
- MSU_FS-01677
- Place of isolation
- Район Тан Фу (Tân Phú districts), Đồng Nai province (Vietnam)
- Placename
- Нам Кат Тьен (Nam Cát Tiên)
- Specimen ID
- 0000000904426
- Species
- Coniothyrium sp.
- Strain
- MSU_FS-01549
- Place of isolation
- Район Тан Фу (Tân Phú districts), Đồng Nai province (Vietnam)
- Placename
- Нам Кат Тьен (Nam Cát Tiên)
- Specimen ID
- 0000000904342
- Species
- Coniothyrium sp.
- Strain
- MSU_FS-01491
- Place of isolation
- Район Тан Фу (Tân Phú districts), Đồng Nai province (Vietnam)
- Placename
- Нам Кат Тьен (Nam Cát Tiên)